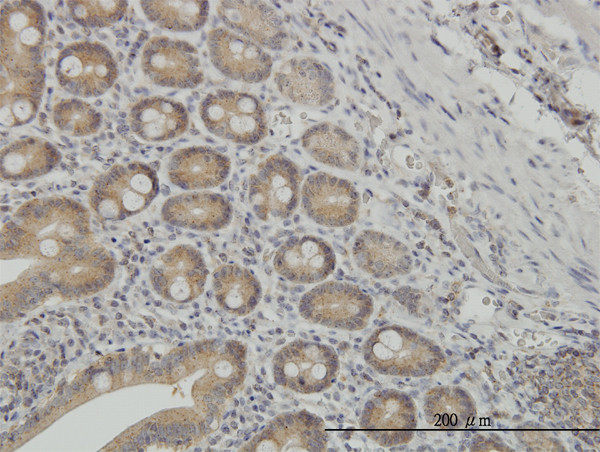
NMI Antibody in Immunohistochemistry (Paraffin) (IHC (P))

Search
Abnova
NMI Monoclonal Antibody (9B8)
{{$productOrderCtrl.translations['antibody.pdp.commerceCard.promotion.promotions']}}
{{$productOrderCtrl.translations['antibody.pdp.commerceCard.promotion.viewpromo']}}
{{$productOrderCtrl.translations['antibody.pdp.commerceCard.promotion.promocode']}}: {{promo.promoCode}} {{promo.promoTitle}} {{promo.promoDescription}}. {{$productOrderCtrl.translations['antibody.pdp.commerceCard.promotion.learnmore']}}
产品信息
H00009111-M03
宿主/亚型
分类
类型
克隆号
抗原
偶联物
形式
浓度
规格
保存条件
运输条件
产品详细信息
Sequence of this protein is as follows: MEADKDDTQQ ILKEHSPDEF IKDEQNKGLI DEITKKNIQL KKEIQKLETE LQEATKEFQI KEDIPETKMK FLSVETPEND SQLSNISCSF QVSSKVPYEI
靶标信息
NMYC interactor (NMI) encodes a protein that interacts with NMYC and CMYC (two members of the oncogene Myc family), and other transcription factors containing a Zip, HLH, or HLH-Zip motif. The NMI protein also interacts with all STATs except STAT2 and augments STAT-mediated transcription in response to cytokines IL2 and IFN-gamma. The NMI mRNA has low expression levels in all human fetal and adult tissues tested except brain and has high expression in cancer cell line-myeloid leukemias.
仅用于科研。不用于诊断过程。未经明确授权不得转售。